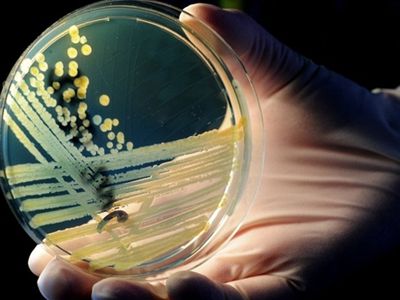
Следы смертельных овощей ведут в Германию - В Мире

ЕС обязал страны признавать однополые браки, заключённые в других государствах
Европейский суд постановил, что страны ЕС обязаны признавать однополые браки, заключённые в других государствах, чтобы обеспечить права на свободу передвижения и семейную жизнь